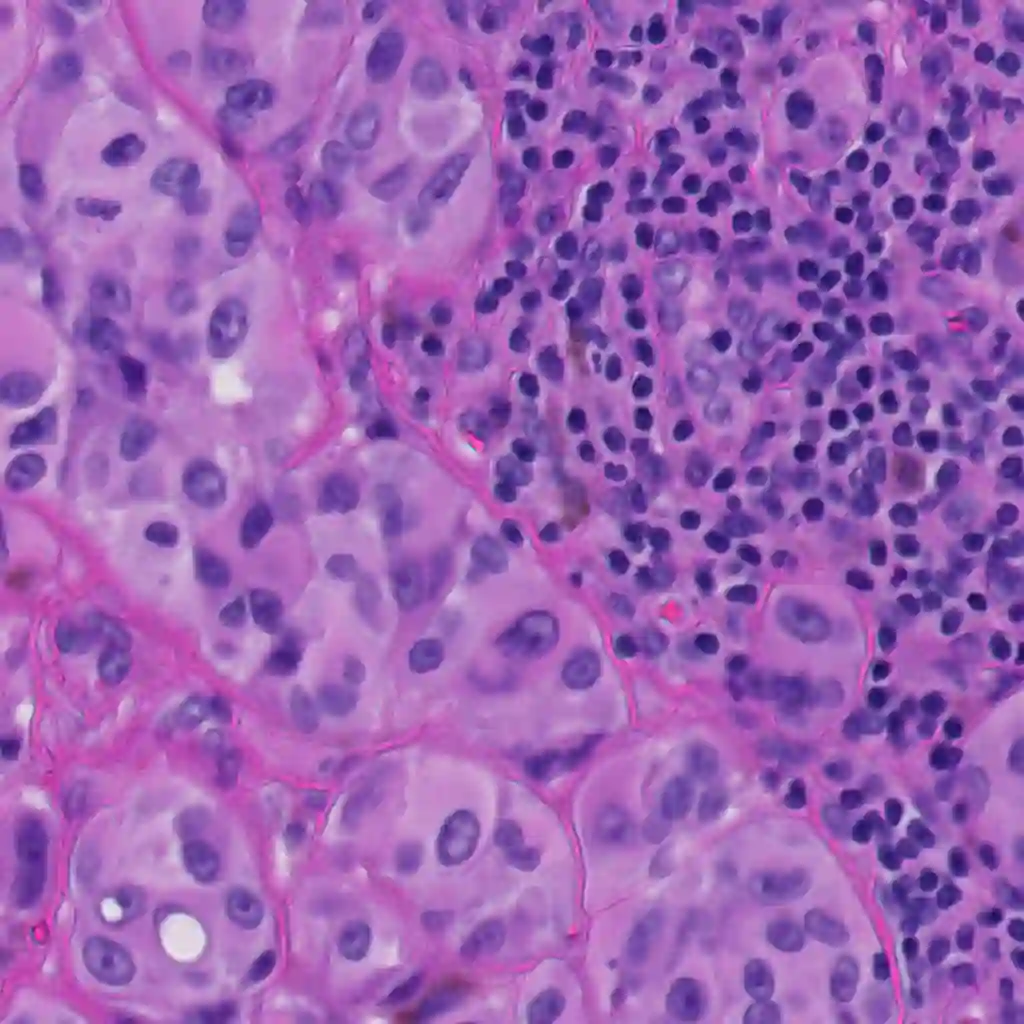

Automated histopathological image analysis plays a vital role in computer-aided diagnosis of various diseases. Among developed algorithms, deep learning-based approaches have demonstrated excellent performance in multiple tasks, including semantic tissue segmentation in histological images. In this study, we propose a novel approach based on attention-driven feature fusion of convolutional neural networks (CNNs) and vision transformers (ViTs) within a unified dual-encoder model to improve semantic segmentation performance. Evaluation on two publicly available datasets showed that our model achieved {\mu}IoU/{\mu}Dice scores of 76.79%/86.87% on the GCPS dataset and 64.93%/76.60% on the PUMA dataset, outperforming state-of-the-art and baseline benchmarks. The implementation of our method is publicly available in a GitHub repository: https://github.com/NimaTorbati/ACS-SegNet
翻译:暂无翻译